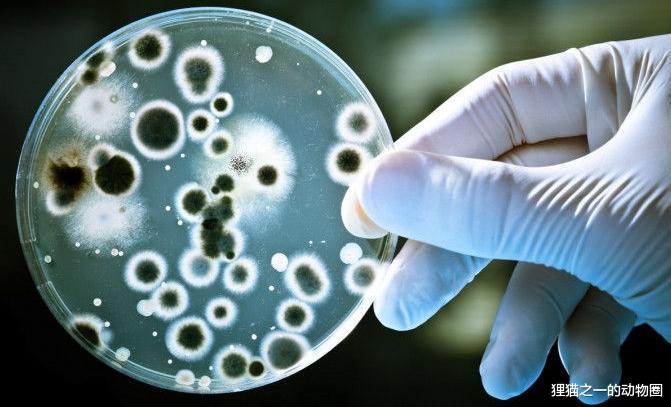
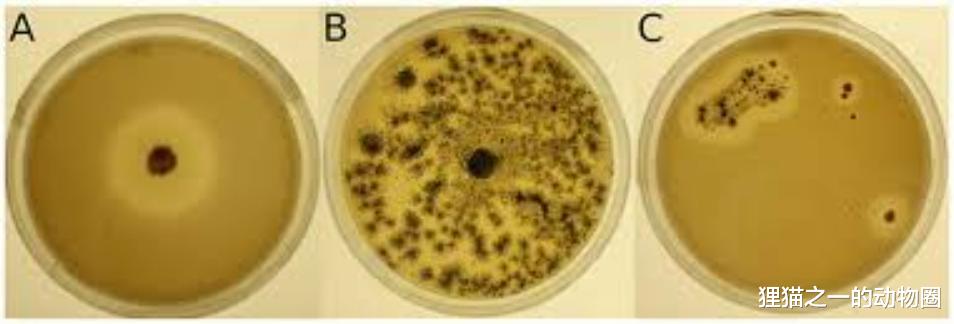

信息来源于letstalkscience、Frontiers、Natre。
虽然全球都在呼吁环保,但塑料污染问题依然是大问题。因为就目前来说,人类的生活是真的离不开塑料,而比起用塑料制品赚钱,处理塑料制品显然没啥收益,所以不出所料,塑料污染问题不断恶化。

据统计,每年有超过1200万吨的塑料会进入水域,其中大部分都进入了海洋。塑料垃圾占据了所有海洋垃圾的80%,各种动物误食了塑料或者被塑料缠住后,都会出现危及生命的情况!
而且你可能不知道的是,塑料垃圾中还有"微塑料"这个分类。微塑料的长度是以微米算的,肉眼都不怎么看得见,这些玩意儿更容易进入食物链,潜移默化的影响所有物种,包括我们人类。

一个空的洗衣液的瓶子就算在海里漂浮几百年也没办法完全消失!
到底该如何处理塑料?除了那些我们都知道的方式,目前科学界一直在尝试用生物降解的方式解决。实际上已经有不少生物被发现可以消化塑料了,基本上近几年每年都能发现几个!那为什么就是不普及下去呢?
坂井氏菌第一个案例是坂井氏菌(Ideonella sakaiensis),听名字你就知道肯定是日本人发现的。这个细菌是在2016年的3月份在日本的一家回收厂发现的,当时有人注意到一些塑料瓶子莫名出现了较为规整的破洞。

坂井氏菌是一种革兰氏阴性杆状细菌,它们自然进化出了消化塑料作为食物的能力,尤其喜欢一种叫作聚对苯二甲酸乙二醇酯(PET)的塑料,这种塑料是很常见用于制作水瓶和食物包装的塑料,那适用性应该很强了吧?
坂井氏菌确实很猛,研究发现它们能直接利用一种名为“水解PET” ( PETase ) 的酶来分解单体之间的键,将较大的分子分解成较小的分子,然后吸收掉。
看起来用这种细菌非常有效啊!为什么没有投入使用?
坂井氏菌确实能分解塑料,但是并不能完全分解,它们只会吸收所需的部分,剩下的还是会排泄出去,而且分解的效率相当慢,就算给全球的塑料垃圾都投放了这种细菌,那也来不及塑料垃圾生产出来的速度。
另外,科学家其实还不够了解这个细菌,没办法制造出那么多的细菌来投放到环境中的塑料。

我觉得最关键的问题在于,坂井氏菌的水解PET一定要在30℃以上的温度环境中才能生效,而这个温度你看着正常,但能稳定保持30℃以上的环境在地球上也就那么些地方。插一句嘴,坂井氏菌不是只吃塑料,它们不靠塑料也能活得很好。
2018年,朴茨茅斯大学的研究人员通过研究水解PET的三维结构,将其改造成“超级酶”,其分解塑料的速度是水解PET的6倍。

奈何本身水解PET速度就慢,翻了6倍其实也不快,而且其他的问题都没有解决。因此这种细菌目前还没办法大规模投入使用,很有可能以后都没办法。
寒冷地带的塑料克星细菌的多样性非常夸张,坂井氏菌非得在30℃以上才能分解塑料,而瑞士联邦科学与技术研究所(WSL)的科学家们则发现了19种耐寒的新型专化细菌和真菌菌株,它们能在15摄氏度的温度下分解可生物降解塑料!

研究人员从样本中分离出微生物后,在15 °C、无光照条件下逐一纯培养,再借助分子手段进行身份鉴定。结果共检出放线菌门与变形菌门下的13个细菌属,以及子囊菌门和毛菌门中的10个真菌属。
这些细菌是在阿尔卑斯山和北极地区发现的,研究成果被发布于《微生物学前沿》杂志上。
那岂不是就能解决坂井氏菌的问题了?可以有效地解决了低温地区的塑料问题了?
可惜的是,这些低温细菌的缺点也很明确,那就是它们只能分解少数特定几种类似的塑料,基本上只能分解聚酯-聚氨酯(PUR)等可生物降解塑料,意思就是泛用性一般。

而且上述的那些难点,这些细菌也就解决了低温分解这个痛点。
蜡虫关于腊虫的新闻我在2021年写过一篇《塑料袋自然降解需200年,它只需几周?科学家发现能以塑料为食的生物》有讲了。不过当时讲得很浅很随意,毕竟刚开始写这类文章。
唉,偷偷感叹一下,都写这么多年了,你看看我这阅读量,纯粹爱好支持了。
说回正题,蜡虫是蜡蛾的幼虫,它们的肠道细菌能够消化低密度聚乙烯(LDPE),这种塑料经常被用于制作购物袋和气泡膜等物品。其唾液中也含有可在室温下氧化、裂解 PE 链的酶,结合肠道细菌能将塑料给转化为体脂。

实验室证明,用2000只蜡虫可以在24小时内完全分解一只聚乙烯(PE)塑料袋,比自然环境下塑料的降解速度快了太多太多了!
优势说完了,接下来说劣势。

虽然蜡虫能吃塑料,但塑料中含有的营养基本上是属于聊胜于无,如果只喂养蜡虫塑料,几天内蜡虫就会体重大幅降低,甚至直接因为摄入营养不足而死亡。所以说不能将蜡虫纯当工具牛马,人类当牛马还能勉强活着,蜡虫当牛马是真的会死。
蜡虫是会排泄的,它们没办法消化的那部分塑料会变成微塑料,如果处理微塑料也是一个需要考虑大问题。

规模化的养殖蜡虫则是另外的一个研究方向了,而且如果只是为了消化塑料而没有产生经济价值,你觉得这样的养殖场有可能建起来吗?也许会有些人以公益的名义投资,但是还得考虑一个问题:大量引入蜡虫,如果工厂建立在其非原生地,也有可能对本地生态造成的新风险。

研究者们都懂这些问题,所以他们其实目前的研究方向主要是对蜡虫分解塑料的生物酶进行分析,想办法在蜡虫体外构建降解体系,期待以后能开发出一种未来可用于降解塑料垃圾的技术。
轮虫这么前沿的研究,怎么可能少得了咱们中国。
中国海洋大学的赵建教授的研究方向就是关于微塑料的,他发现轮虫能够分解微塑料!

好家伙!就看到现在这边,有没有感觉这些研究能互补?如果能整合起来岂不是无敌了?但其中的艰难根本是我们这些普通人难以想象的。
体长不过0.5毫米的轮虫分布于全球的所有地表水当中,我国最大的淡水湖鄱阳湖中,预估每升湖水就有900只轮虫!这些轮虫的咀嚼器能将藻类碎成小块然后吃掉,方便消化。它们同样可以用这种方式消耗微塑料。

轮虫是如何消化微塑料的目前还有待研究,不过问题其实非常显著,而且之前的案例就出现过了。
吃了就会拉啊,这个没办法。轮虫吃了微塑料后,也是只会吸收有用的,其他的部分就变成更小的微塑料被排放出去,变得最小只有3微米的纳米级微塑料!这些纳米级微塑料的危害更是难以察觉了!

听起来跟来捣乱的一样,但它们确实是能消化塑料的,无论如何如果能研究透彻了,肯定是能有处理塑料垃圾方面的收获的。




